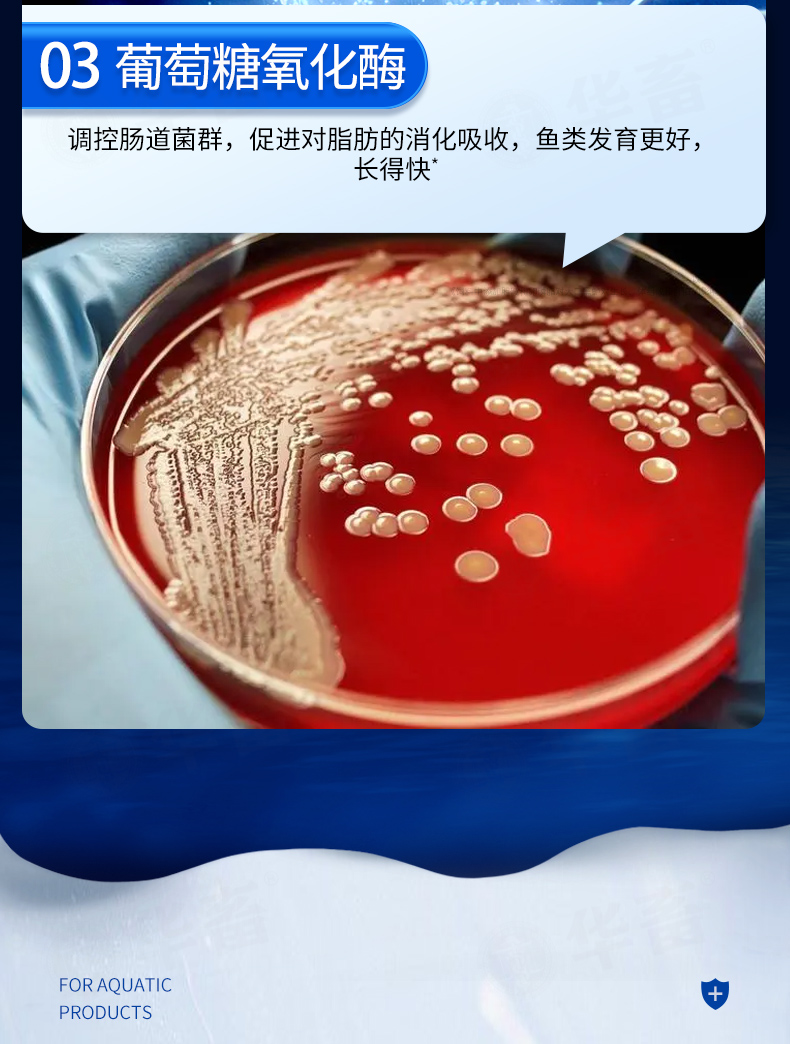

【积分兑换】华畜肝胆宁200g 改善采食 减少应激 保护肝脏 不易生病
¥11.90 - 267.00
| 运费: | ¥ 0.00-999.00 |
| 库存: | 16455 件 |
商品详情

- 华畜官方微信旗舰店 (微信公众号认证)
- 扫描二维码,访问我们的微信店铺
- 随时随地的购物、客服咨询、查询订单和物流...
















